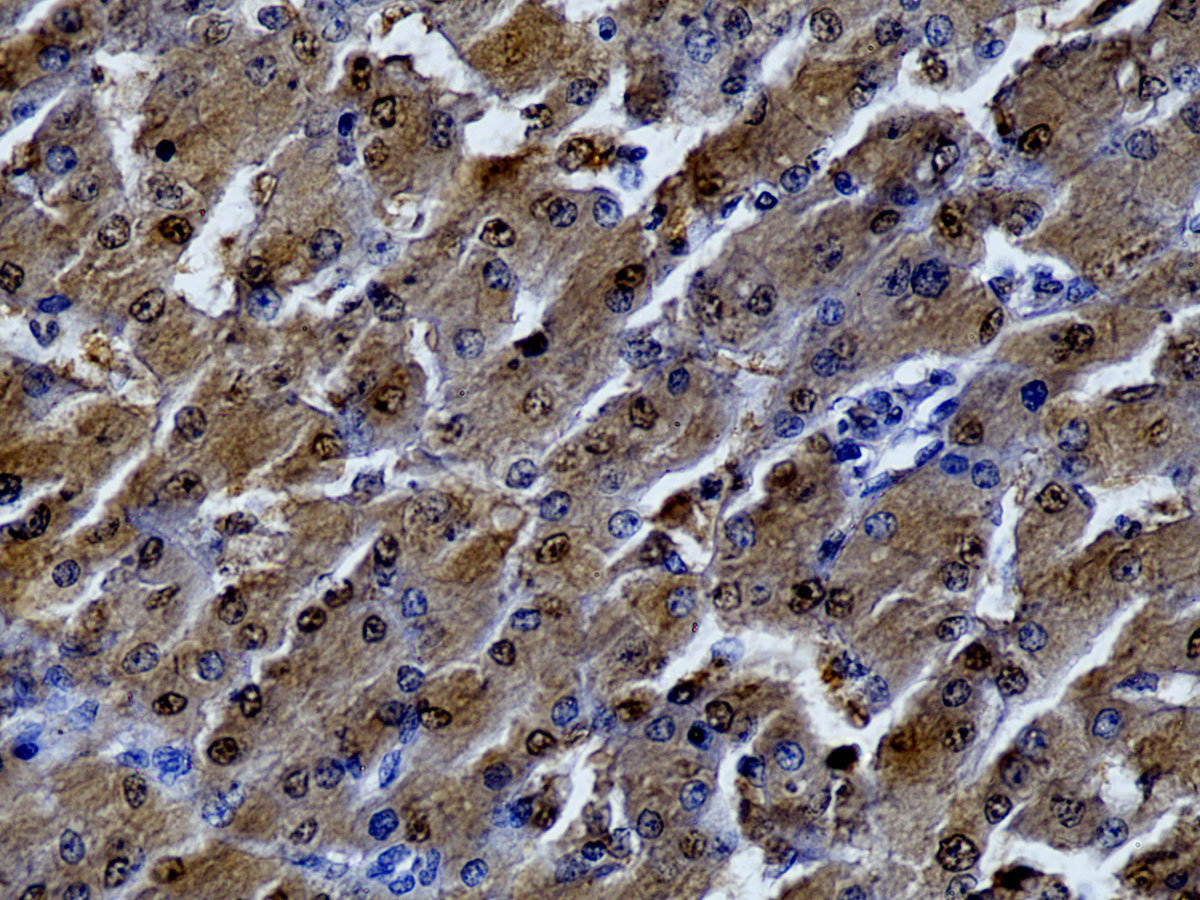

Search our suppliers catalog
BioGenex
BioGenex
News about BioGenex
| Anti-Arginase 1, Clone C-2 |
| Arginase 1 (also known as liver type arginase or Type 1 arginase, ARG1) is a 35-40 kDa member of the arginase family of enzymes that catalyzes the breakdown of L-arginine into ornithine and urea. It demonstrates two distinct functions: it catalyzes the conversion of arginine to ornithine and urea in the hepatocyte cytoplasm, while in multiple cells, it degrades arginine, thus indirectly downregulating Nitric Oxide synthase activity by depriving this enzyme of its substrate. It is a highly expressed cytosolic enzyme in the liver and other tissues, including the brain. Arginase 1 also appears to play critical roles throughout the CNS for survival and regeneration of neurons and axons. Arginase 1 is an excellent marker for hepatocytes and used in differential diagnosis of Hepatocellular carcinoma from metastatic tumors of the liver. View Product Datasheet Click on image to enlarge |
![]() |
| Anti-TIM3, Clone TIM3/3113 |
| T-cell immunoglobulin and mucin domain 3 (TIM3) is a member of immunoglobulin (Ig) and mucin domain (TIM) family, comprised of type-I cell surface glycoproteins. TIM3 expressed on interferon (IFN)-gamma (γ) secreting helper T (Th) cells, regulatory T cells (Tregs), CD8 + T cells, Dendritic cells (DCs), monocytes, and other leukocyte subsets, including natural killer (NK) cells. TIM3 plays a key role in inhibiting both adaptive and innate immune responses, potentially exerting either positive or negative effects, thus acting as an immune modulator. In chronic inflammation, autoimmune disorders, and some cancers, While on activated T cells, CEACAM1 and Tim3 are co-expressed and form a heterodimer to suppress T cell function and down regulate its anti-tumor immunity. View Product Datasheet Click on image to enlarge |
![]() |
Info BioGenex
The Molecular Pathology Specialist.
BioGenex designs, develops and commercializes molecular pathology systems for Tumor diagnosis, prognosis, precision medicine and life science research. BioGenex prides itself on delivering cutting edge technology, years ahead of the competition, providing the finest systems for immunohistochemistry (IHC). BioGenex systems and product performance are guaranteed: antibodies, antigen retrieval, detection systems, and histology stains. We provide quality systems and are committed to best in class customer care.
Currently there are no products of the brand BioGenex in our catalog.